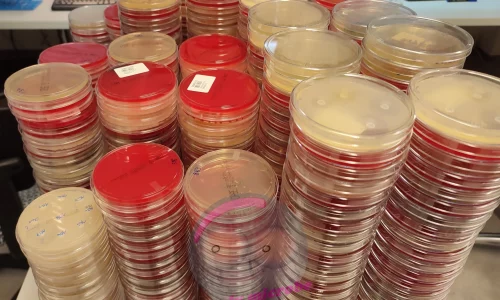

Mikrobiologie leicht erklärt: Nährmedien, ihre Typen und Anwendungen
Ich gebe zu, in diesem Jahr war ich mit meinen Blogbeiträgen etwas nachlässig, das soll sich aber ändern!
Eine Beitragsreihe, die ich schon lange geplant habe, widmet sich den Nährmedien im Labor. Ich möchte euch die verschiedenen Medien vorstellen, erklären, worin ihre Unterschiede liegen und warum es heute so viele unterschiedliche Nährmedien gibt.
Heute gibt es zunächst einen kleinen Überblick, und in den kommenden Wochen werde ich euch Schritt für Schritt einzelne Agarplatten genauer vorstellen.
Wie macht man Bakterien im Labor sichtbar?
Damit wir Bakterien im Labor sichtbar machen und untersuchen können, brauchen sie die passenden Lebensbedingungen also ihre ganz eigene „Wohlfühlumgebung“. Die meisten medizinisch relevanten Bakterien lassen sich dafür recht gut auf künstlichen Nährmedien anzüchten.
Dafür stehen unterschiedliche Medien zur Verfügung: flüssige Medien (auch Bouillon genannt) oder feste Medien. Die meisten Mikroorganismen bevorzugen ein feuchtes Milieu, das ihnen Wachstum und Vermehrung ermöglicht.
Natürlich gibt es auch ein paar Sonderfälle, obligat intrazelluläre Bakterien wie Chlamydien brauchen lebende Zellen und wachsen daher nur auf Zelllinien. Rickettsien sind noch anspruchsvoller, sie lassen sich ausschließlich in Versuchstieren oder bebrüteten Hühnereiern vermehren. Heutzutage sind aber viele dieser Bakterien auch mit molekularbiologischen Methoden wie PCR nachweisbar.
Nährstoffe
Bakterien und Pilze benötigen, genau wie wir Menschen, verschiedene Nährstoffe, um wachsen und sich vermehren zu können.
Bei Bakterien im medizinisch-diagnostischen Bereich besteht die Hauptnahrungsquelle meist aus Kohlenstoff- und Stickstoffverbindungen, insbesondere in Form von Aminosäuren und Peptiden (also Eiweißbausteinen). Häufig findet man in Nährmedien den Bestandteil Pepton, dabei handelt es sich vereinfacht gesagt um kürzere Aminosäureketten und Peptide mit geringer Molekülmasse, die zuvor durch Säuren oder Enzyme aufgespalten wurden. Als Ausgangsstoffe dienen häufig Casein (ein Milchprotein), Soja oder Fleischextrakte. Weitere Bestandteile können Mineralsalze wie Phosphor, Schwefel, Magnesium und Kalzium, Metalle (vor allem Eisen), Vitamine und natürlich Wasser sein. Ein entscheidender Punkt ist auch der pH-Wert. Die meisten Bakterien fühlen sich bei einem neutralen pH-Bereich um 7 am wohlsten.
Pilze hingegen haben etwas andere Ansprüche. Für ein gutes Wachstum benötigen sie zusätzlich Zucker, der in Nährmedien meist in Form von Glucose, Malz oder Dextrose enthalten ist. Ein bekanntes Beispiel aus dem Alltag ist das Backen. Hefe, also der Pilz Saccharomyces cerevisiae (oder S. carlsbergensis beim Bierbrauen), braucht Zucker, um aktiv zu werden. Gibt man Zucker zum Teig, beginnt die Hefe zu „arbeiten“, sie verstoffwechselt den Zucker, produziert Gase und lässt den Teig aufgehen. Genau so nutzt der Pilz im Labor seine Zuckerquelle, um zu wachsen.
Flüssignährmedien (Bouillons)
Bouillons dienen meist als zusätzliches Anreicherungsmedium, wenn Bakterien aus verschieden Gründen auf festen Nährmedien nicht mehr oder schlecht anwachsen. Ich stelle euch hier zwei gängige Boullions vor, mit denen ich auch gearbeitet habe. Aber es gibt noch einige mehr.
Thioglykolat Boullion
Ganz allgemein lässt sich sagen, mit dieser Nährbouillon kann man Bakterien nach ihrem Sauerstoffbedarf unterscheiden. Es gibt obligat aerobe (sauerstoffliebende) und obligat anaerobe (sauerstoffempfindliche) Bakterien sowie fakultativ anaerobe, mikroaerophile und aerotolerante Mikroorganismen. Wie der Name schon verrät, enthält das Medium neben den schon besprochenen Nährstoffen auch Thioglykolat, eine Substanz, die den gelösten Sauerstoff reduziert. Dadurch entsteht ein Milieu, in dem auch anaerobe und mikroaerophile Bakterien wachsen können. Das Wachstum erkennt man an der Trübung der Bouillon. Je nachdem, in welchem Bereich des Röhrchens die Bakterien wachsen, lässt sich ihr Sauerstoffverbrauch ableiten. Wichtig ist, vor der Auswertung darf die Bouillon auf keinen Fall geschüttelt werden, da sich sonst der Sauerstoff im Medium neu verteilt – und das Ergebnis verfälscht wird.
Je nach Hersteller können Thio Bouillons auch den Farbstoff Resazurin enthalten, ein Oxidationsindikator, der sich je nach Sauerstoffgehalt verfärbt.
https://en-m-wikipedia-org.translate.goog/wiki/Thioglycolate_broth?_x_tr_sl=en&_x_tr_tl=de&_x_tr_hl=de&_x_tr_pto=rq
Todd Boullion
Die Todd-Hewitt-Bouillon (oft einfach Todd-Bouillon genannt)wurde ursprünglich entwickelt, um das Wachstum von β-hämolysierenden Streptokokken zu fördern. Aber auch Penumokokken oder Enterokokken kann man in diesem Nährmedium anzüchten. Die Zusammensetzung ist besonders nährstoffreich, Peptone, Glucose, Hefeextrakt und Natriumchlorid liefern alles, was empfindliche Bakterien für ein gutes Wachstum brauchen. Durch Puffer wie Natriumbicarbonat und Natriumhydrogenphosphat wird der PH-Wert reguliert, denn bei der Verwertung von Glucose entsteht Säure, die das von Streptokokken gebildete Hämolysin zerstören würde.
Manchmal wird die Todd-Bouillon auch als Anreicherungsmedium genutzt, zum Beispiel, wenn in einer Probe nur wenige Streptokokken vorhanden sind. Mit speziellen Zusätzen (z. B. Gentamicin und Nalidixinsäure) kann man auch bestimmte Bakterien selektiv unterdrücken.
Feste Nährmedien – die Welt der Agarplatten
Nachdem wir uns die flüssigen Nährmedien angeschaut haben, kommen wir jetzt zu den festen Medien, den sogenannten Agarplatten. Sie sind wohl das, was man sich klassischerweise unter „Bakterienkulturen“ vorstellt, kleine, teils bunte Kolonien auf einer festen Oberfläche.
Zur Verfestigung wird meist Agar-Agar verwendet. Im Gegensatz zu Gelatine kann Agar von den meisten Bakterien nicht enzymatisch abgebaut werden. Das hat einen großen Vorteil: Das Medium bleibt stabil, und die Bakterien wachsen zuverlässig genau dort, wo sie sollen ohne das Medium zu verflüssigen oder sich unkontrolliert auszubreiten. Agarplatten bieten also eine strukturierte Oberfläche, auf der sich einzelne
Bakterienzellen voneinander trennen und zu sichtbaren Kolonien heranwachsen können. So lassen sich verschiedene Arten unterscheiden und gezielt weiter untersuchen.
Universalmedien
Universalnährmedien bieten ein besonders reichhaltiges Nährstoffangebot, das vielen unterschiedlichen Bakterienarten das Wachstum ermöglicht. Sie enthalten keine wachstumshemmenden Zusätze und dienen daher als ideale Grundlage, um ein möglichst breites Spektrum an Mikroorganismen anzuzüchten.
Für die Herstellung werden komplexe Ausgangsstoffe verwendet – dazu gehören Fleisch- und Hefeextrakte, Peptone, Serum und Blut (in der Regel Schafblut, seltener Pferdeblut). Diese Mischung liefert den Bakterien alles, was sie für ihr Wachstum benötigen.
Auf solchen Nährböden wachsen in der Regel alle gängigen, kultivierbaren Bakterien, die im medizinisch-diagnostischen Alltag eine Rolle spielen. Zu den bekanntesten Vertretern gehören der Blutagar (Columbia Agar) und der Müller-Hinton-Agar, die in fast jedem mikrobiologischen Labor zu finden sind.
Optimalnährmedien – wenn Bakterien es besonders anspruchsvoll mögen
Während Universalnährmedien schon vielen Mikroorganismen ein gutes Wachstum ermöglichen, gibt es einige Bakterienarten, die noch etwas „mehr“ brauchen. Für diese empfindlichen oder besonders nährstoffbedürftigen Keime werden sogenannte Optimalnährmedien eingesetzt.
Dabei werden die wachstumsfördernden Eigenschaften der Universalnährmedien durch zusätzliche Supplemente verbessert etwa durch Hämin, Fildes-Extrakt (gewonnen aus defibriniertem Schafblut durch Pepsinverdau), Vitamine und Spurenelemente. Diese Zusätze schaffen ideale Bedingungen, damit auch anspruchsvolle Bakterien, wie etwa die Vertreter der HACEK-Gruppe (Haemophilus aphrophilus und Haemophilus paraphrophilus, Aggregatibacter actinomycetemcomitans, Cardiobacterium hominis, Eikenella corrodens und
Kingella kingae) zuverlässig wachsen können. Typische Beispiele für solche Nährmedien sind der PVX-Agar oder der HAEM-Agar, die speziell für die Kultivierung von empfindlichen Erreger entwickelt wurden.
Selektivnährmedien
Manchmal möchte man im Labor nicht alle Bakterien zum Wachsen bringen, sondern gezielt bestimmte Arten fördern und andere unterdrücken. Genau dafür gibt es Selektivnährmedien. Diese Medien sind so zusammengesetzt, dass nur bestimmte Mikroorganismen die darin enthaltenen Nährstoffe nutzen können. Durch chemische Zusätze wie Natriumazid, Tellurit, Kristallviolett oder Brillantgrün oder durch den Einsatz von Antibiotika wie Kanamycin, Vancomycin, Gentamicin, Chloramphenicol oder Colistin wird das Wachstum unerwünschter Begleitkeime gezielt gehemmt. So können empfindliche oder seltene Erreger besser erkannt und isoliert werden, ohne von schnell wachsenden Konkurrenzkeimen überwuchert zu werden. Typische Beispiele für solche Selektivmedien sind der CNA-Agar (Colistin-Nalidixinsäure-Agar), bei dem das Wachstum gramnegativer Bakterien unterdrückt wird und der Schaedler-KV-Agar für obligat anaerobe Bakterien. Wobei der KV Agar (Kanamycin/ Vancomycin) das Wachstum von grampositive Bakterien hemmt.
Differentialnährmedien
Differentialnährmedien sind so konzipiert, dass mehrere Mikroorganismen gleichzeitig wachsen können, sie sich aber durch sichtbare Unterschiede in Kolonien oder Farbe eindeutig voneinander unterscheiden lassen. Typische Beispiele sind CPSE-Agar oder MacConkey-Agar (MCK).
Manche Nährmedien vereinen gleich zwei Eigenschaften. Sie können zB sowohl selektiv als auch differential sein. Ein klassisches Beispiel dafür ist der MacConkey-Agar, der gezielt das Wachstum bestimmter Bakterien fördert und gleichzeitig Unterschiede zwischen ihnen sichtbar macht.
Ich hoffe, ich konnte euch einen guten Überblick über die verschiedenen Nährmedien geben und zeigen, warum sie für die Arbeit im Labor so wichtig sind. In den nächsten Beiträgen werde ich dann einzelne Agarplatten und ihre Besonderheiten genauer vorstellen – bleibt gespannt!
Wer Lust hat kann sich gern auch noch den Blogbeitrag zur Einführung in die mediizinische Mikrobiologie anschauen.